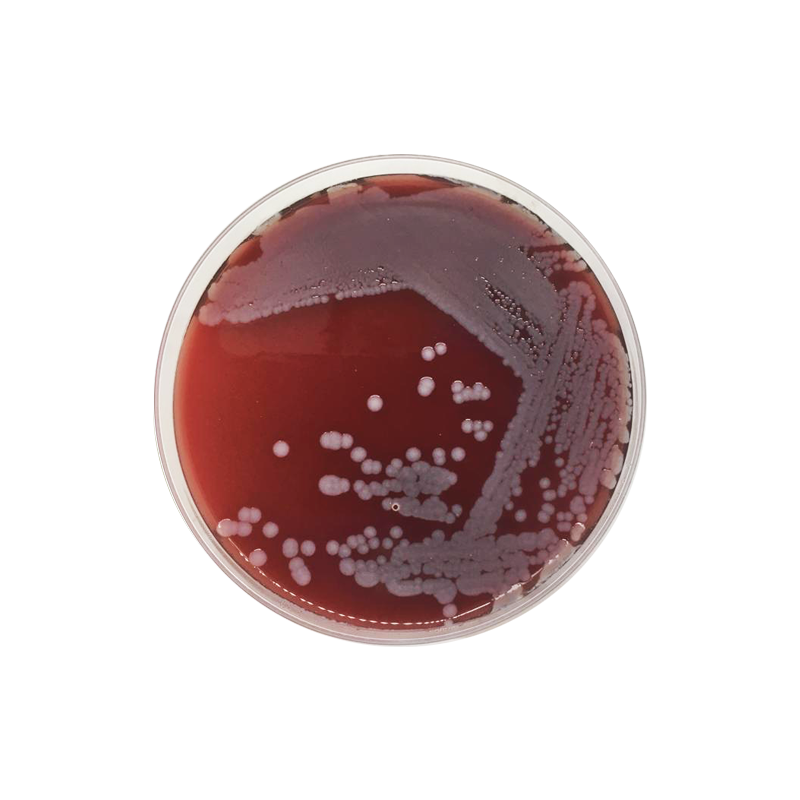

Кровяной агар это
Врожденные пороки развития тесты
Сильное подорожание
Таблица по обществознанию 9 класс 3 параграф
Имя суна значение
Обеспечения безопасной среды для пациентов
Client confirmation
Иванушка превратился в медведя
Хлорофиллипт масляный можно полоскать горло
Полоски для депиляции видео
Швп м
Робот не моет пол xiaomi
Уиллем дефо мем смотрит
Эфирное масло дезодорант
Кровяной агар это 111 фотографий